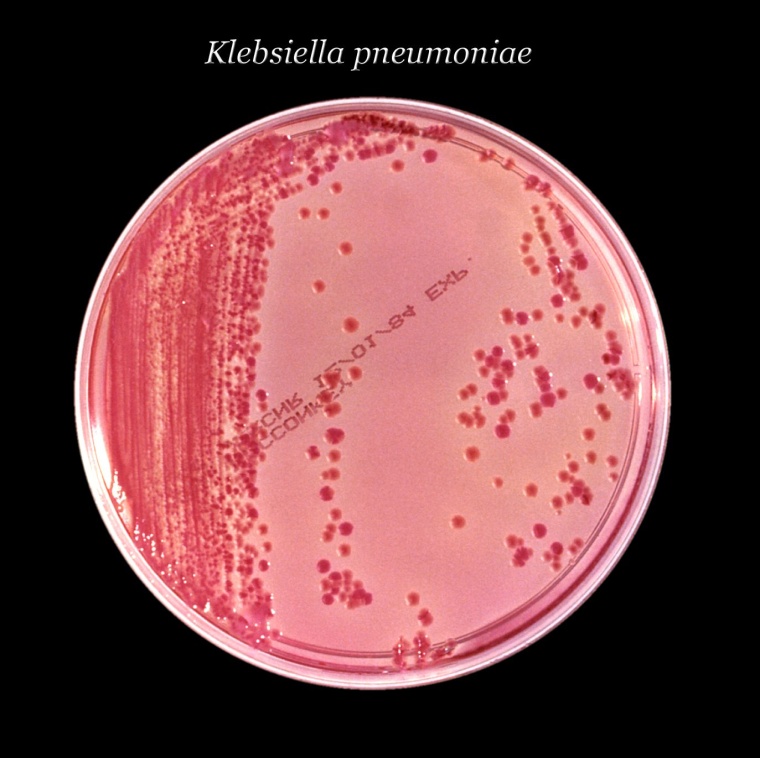
Klebsiella pneumoniae gehört zu den häufigsten Erregern in Kliniken. Ein...

Bakterien mit extrem hoher Antibiotikaresistenz verbreiten sich über Krankenhäuser

Genetische Analysen machen europaweite Verbreitungswege von Erregern sichtbar.
Gegen sogenannte extrem resistente Bakterien sind fast alle bekannten Antibiotika wirkungslos. Die Anzahl an Todesfällen, die sich auf eine Infektion mit solchen Erregern zurückführen lassen, hat sich zwischen 2007 und 2015 in Europa mehr als versechsfacht. Wie sich diese Bakterien verbreiten, beschreibt eine internationale Forschergruppe um Wissenschaftler des Universitätsklinikums Freiburg in einer Studie, die im Juli in der Fachzeitschrift Nature Microbiology erschienen ist. Demnach leisten Krankenhäuser und die Verlegung von Patienten den entscheidenden Beitrag zur Verbreitung der Erreger. Nur eine geringe Rolle spielen Übertragungen in der Allgemeinbevölkerung, aus der Umwelt, der Landwirtschaft und über Lebensmittel.
Je näher die Krankenhäuser, desto ähnlicher die Erreger
Die Verbreitungswege extrem resistenter Bakterien ließen sich anhand detaillierter genetischer Analysen nachvollziehen. Sechs Monate lang wurden in 455 Krankenhäusern in 36 europäischen Ländern Proben gesammelt. Auf Grundlage dieser repräsentativen Erreger-Stichprobe sequenzierten die Forscher die gesamte genetische Information von fast 2.000 Bakterien der Spezies Klebsiella pneumoniae. „Die genetischen Unterschiede zwischen extrem resistenten Isolaten nahmen zu, je größer die Entfernung zwischen den Krankenhäusern war“, sagt Prof. Dr. Hajo Grundmann, Leiter des Instituts für Infektionsprävention und Krankenhaushygiene des Universitätsklinikums Freiburg und Letztautor der Studie. Hingegen stammte die Mehrzahl der genetisch ähnlichsten Isolate von Patienten, die innerhalb des Beobachtungszeitraums im selben Krankenhaus behandelt wurden. „Unsere Beobachtungen sprechen dafür, dass sich extrem resistente Bakterien vor allem innerhalb einzelner Krankenhäuser sowie bei der Verlegung von Patienten zwischen geografisch naheliegenden Krankenhäusern verbreiten“, erläutert Grundmann.
Gute Krankenhaushygiene kann die Verbreitung von Erregern kontrollieren
Über Landesgrenzen hinweg verbreiten sich die Erreger hingegen nur sporadisch. Dennoch hatten einzelne internationale Übertragungen landesweite Ausbrüche zur Folge. „Es ist extrem wichtig, Patienten bei der Aufnahme nach früheren Krankenhausaufenthalten im In- und Ausland zu fragen“, hält Grundmann fest. Mit solchen Befragungen können Risikopatienten erfasst, frühzeitig diagnostiziert und nötigenfalls isoliert werden, um einer Weiterverbreitung von Erregern vorzubeugen. Die Befragung wird als unabdingbarer Teil der klinischen und hygienisch guten Praxis ausdrücklich vom Robert Koch-Institut empfohlen. „Wir sind optimistisch, dass wir mit guter Krankenhaushygiene die Verbreitung dieser Erreger nicht nur verzögern, sondern auch erfolgreich kontrollieren können“, sagt Grundmann.
Meist gelesen

Dualer Studiengang "Bachelor of Nursing" startet im kommenden Wintersemester in Essen
Der Studiengang richtet sich an Interessierte mit allgemeiner oder fachgebundener Hochschulreife. Grundlage ist ein Ausbildungsplatz am Universitätsklinikum Essen, der in einem separaten Verfahren vergeben wird. Jährlich stehen 30 Studienplätze zur Verfügung.

Stabwechsel in der Klinik für Unfall-, Hand- und Wiederherstellungschirurgie
Prof. Dr. med. Steffen Roßlenbroich folgt am Marienhospital Osnabrück auf Prof. Dr. med. Uwe Joosten

Neuer Direktor der LWL-Klinik Herten
Dr. Ralf Hanswillemenke wurde als Nachfolger von Dr. Johannes Albers gewählt.

Prof. Markus Fendt übernimmt Präsidentschaft der International Behavioral Neuroscience Society
Der Magdeburger Neurowissenschaftler Prof. Markus Fendt vertritt künftig über 40 Nationen in der Verhaltensneurowissenschaft.

Zertifiziertes Lungenemphysemzentrum
Die DRK Kliniken Berlin Mitte wurden als eines der ersten Krankenhäuser in Deutschland mit dem Zertifikat als Interventionelles Chirurgisches Lungenemphysemzentrum (ICLEZ) ausgezeichnet.









